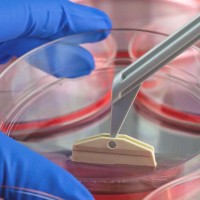
Gallery thumbnail

IV Amino Acids
About
Fight off the free radicals in your body and slow down aging and common disorders with our amino acid or Glutathione drips. While we all need oxygen to live, did you know that too much oxygen can cause free radicals to develop in the body? These free radicals then move on to damage parts of our body and often lead to disorders, diseases, and aging, which we all want to avoid. You can control these free radicals quickly and put an end to them with our antioxidant therapy.
Our antioxidant IV therapy targets Glutathione and helps remove free radicals from your body to prevent aging and allow you to glow. If you would like to receive treatment, do not hesitate to call today. All antioxidant treatments are done via IV and absorbed 100% into your bloodstream and body.
Glutathione and amino acids are known to help re-build and repair your tissues. Over time, our tissues break down, especially when we work out or we have been sick for some time. Antioxidant therapy can provide you with that boost you need to re-build some of the tissues in your body.
Images